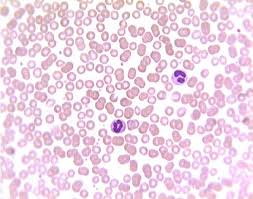
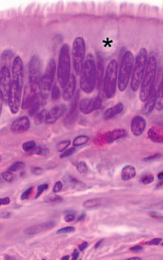

1/35
Looks like no tags are added yet.
Name | Mastery | Learn | Test | Matching | Spaced |
|---|
No study sessions yet.

simple cuboidal epithelia

transistional epithelia

loose aerolar connective tissue

hyaline cartiledge


fibrocartiledge

hyaline cartiledge

hyaline cartiledge

bone

bone

bone
blood

blood

thick skin

simple cuboidal epithelia

simple columnar epithelia

pseudostratisfied columnar
pseudostratified columnar

simple squamous epithelia

simple squamous epithelia

stratified squamous epithelia

stratified squamous epithelia (keratinzed)

stratified cuboidal epithelia

stratified columnar epithelia

transisitional epithelia

transisitional epithelia

transisitonal epithelia

skeletal muscle

cardiac muscle

smooth muscle

neuronal cell bodies and glial cells

neuronal cell bodies and glial cells

hyaline cartiledge

thin skin

thin

thick